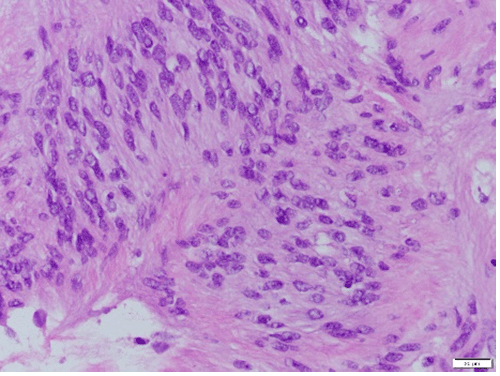
Haemotoxylin and eosin (H&E) staining at 40x magnification demonstrates characteristic hypercellular palisading pattern around fibrillary process commonly found in schwannomas

Abstract
Background
Gastric schwannomas are an extremely rare type of gastrointestinal (GI) mesenchymal tumor that can clinically and grossly mimic features of other GI tumors, including gastrointestinal stromal tumors (GIST).
Summary
A 62-year-old female was incidentally found to have a 5 cm mass on the lesser curvature of the stomach. Workup of the mass included imaging via computer tomography (CT), GI endoscopy, and endoscopic ultrasound (EUS). Initial pathology misidentified the lesion as a gastric hemangioma. Given the size and characteristics of the mass, the patient was offered laparoscopic resection of the lesion. Final pathology revealed the mass to be a gastric schwannoma, with immunohistochemistry demonstrating positive expression of S100 and SOX10.
Conclusion
Gastric schwannomas are an extremely rare type of GI mesenchymal tumor that should be considered in the differential diagnosis when encountering gastric masses. Patients can present entirely asymptomatic or with a wide array of non-specific gastric symptomatology. Imaging of the mass may also be inconclusive as the lesion can mimic the physical features of GIST but can be easily distinguished with S-100 immunohistochemical staining. Correctly identifying the underlying pathology affords patients prognostic information as the behavior of gastric schwannomas is drastically different from other gastric malignancies.
Key Words
schwannoma; stomach; partial gastrectomy; mesenchymal tumor
Case Description
Schwannomas are tumors of mesenchymal origin that can occur in peripheral nerve sheaths throughout the body. These tumors rarely develop in the gastrointestinal system and are generally benign.1 Gastric schwannomas represent a diagnostic challenge in that they physically mimic other stromal and mesenchymal tumors. In the following sections, we will discuss a rare case of an incidentally discovered gastric schwannoma and our diagnostic and therapeutic approach.
A 62-year-old female with a history of gastroesophageal reflux disease and a 50+ pack year smoking history underwent surveillance chest CT for pulmonary nodules when an incidentally discovered gastric mass was noted. This finding was confirmed with dedicated abdominal and pelvic CT, which demonstrated a 4.1 × 4.3 cm partially exophytic mass on the lesser curvature of the stomach, roughly 9 cm from the gastroesophageal junction (Figure 1). The mass was well circumscribed with no invasion into adjacent structures. Based on the location of the mass and its homogenous appearance on imaging, our initial diagnosis was that of a gastrointestinal stromal tumor (GIST). Apart from the patient’s long-standing reflux disease, she denied any other gastric symptoms.
Figure 1. Dedicated CT Scan of Abdomen and Pelvis After Incidental Discovery of Gastric Mass. Published With Permission
Figure 2. Images of Ultrasound and Upper GI Endoscopy. Published With Permission.
To better characterize the mass, the patient was referred for upper GI endoscopy. The study demonstrated a subepithelial lesion on the lesser curvature of the stomach with an area of central umbilication. The patient also underwent endoscopic ultrasound (EUS), which showed a 3.5 × 3.2 cm, hypoechoic, multicystic, septated mass (Figure 2). The lesion appeared to originate from the muscularis propria with well-defined borders. Multiple biopsies were taken, and tissue was sent for pathologic interpretation. Immunohistochemistry (IHC) was performed, which stained positive for CD31 and negative for c-KIT, PDGFR, and DOG-1. CD31 positivity suggested this to be a highly vascular lesion as CD31 is an endothelial cell marker. The lack of expression of c-Kit, PDGFR, and DOG-1 made our presumptive diagnosis of a GIST less likely. Importantly, staining for S-100 was not performed at this juncture. Thus, the working pathological diagnosis was gastric hemangioma. The mass, however, did not appear to have the physical characteristics of hemangioma during endoscopic visualization. Given the size and the endoscopic characterization of the mass, the decision was made to offer the patient surgical resection of the lesion without a definitive diagnosis.
The patient underwent a gastric wedge resection via a laparoscopic approach. During exploration, a 5 × 5 × 5 cm fungating mass was identified on the lesser curvature of the stomach and resected. An intraoperative upper GI endoscopy was performed following the resection, and no additional gastric lesions were identified. The patient had an uneventful postoperative course and was discharged on postoperative day 1 without complication.
A macroscopic examination of the specimen revealed non-necrotic tissue with multiple cystic spaces containing hemorrhagic material. Pathology of the specimen identified the mass as a gastric schwannoma with a characteristic hypercellular palisading pattern around a fibrillary process on hemotoxylin and eosin (H&E) staining. IHC demonstrated diffuse positive expression of S100 and SOX10, confirming the diagnosis of gastric schwannoma (Figure 3).
Figure 3. Histopathology and Immunohistochemistry Analysis of Gastric Mass. Published With Permission
At her postoperative clinic visit, the patient was doing well without any immediate complications from her surgical procedure. The pathology of the surgical specimen was discussed with her in detail, and the decision was made for a follow-up CT scan in one year to evaluate for recurrence.
Discussion
Stromal and mesenchymal masses of the gastrointestinal tract generally occur as subepithelial tumors. The most common type is a GIST, which is commonly identified via IHC by the expression of markers c-KIT and CD34.2 Other GI mesenchymal tumors are far less common and include neoplastic cells derived from various cell types. Gastric schwannomas are a rare type of GI mesenchymal tumor and account for 0.02% of all gastric tumors.3 Schwannomas are spindle cell mesenchymal tumors derived from Schwann cells, a type of glial cell that functions in myelinating axons in the peripheral nervous system. While schwannomas can grow in any nerve sheath containing Schwann cells, they are rarely found in the digestive tract. When they do occur in the gastrointestinal tract, the most common location is the stomach.1 These tumors generally present in adults with a mean age of 58 and are commonly asymptomatic, though patients can also present with an array of non-specific gastric symptomatology.4 Although gastric schwannomas can clinically and grossly mimic features seen in GIST, it is vital to correctly diagnose these tumors as they are generally benign and carry a favorable prognosis following curative surgical resection.5
When a gastric mass is encountered, a differential including GIST, leiomyoma, leiomyosarcoma, and gastric schwannoma should all be considered. While a definitive diagnosis of gastric schwannoma requires a pathologic specimen, many imaging techniques can aid in the characterization of the tumor and help narrow the differential prior to resection. On CT, gastric schwannomas appear homogeneous, which is helpful in distinguishing them from other tumor types, such as leiomyomas and leiomyosarcomas, which appear more heterogeneous. Upper GI endoscopy with EUS can help determine which layer the mass originates from and can help better characterize the lesion. MRI may also provide some benefit as it can highlight the spatial relationship of the tumor to surrounding tissues and vessels6 while also potentially demonstrating identifying characteristics such as high signal intensity on T2-weighted MRI images.7 CT with distension technique (PnCT) can also aid in preoperative planning as this technique better defines tumor location, dimensions, and local invasion.8 After a pathologic specimen is obtained, IHC helps make the definitive diagnosis. GIST tumors generally stain positive for CD117 (c-KIT), DOG-1, and CD34, whereas leiomyoma expresses CD34, SMA, and desmin. Schwannomas characteristically have a positive expression for S100, PKC-theta, and GFAP.9‒11
Although gastric schwannomas are benign and often asymptomatic, complete surgical resection is the treatment modality of choice and is considered curative. The extent of gastric resection depends mainly on the location and size of the mass. Wedge resections for tumors located on the lesser curvature are performed at our institution if a resection can be performed without clinically significant luminal narrowing. While ensuring adequate blood supply to the remaining stomach is imperative, the redundancy of the gastric vasculature is often sufficient to maintain adequate tissue perfusion postoperatively for lesser curvature wedge resections. Complete resection can usually be achieved with a laparoscopic approach, and because lymphatic invasion is exceedingly rare with these tumors, concurrent lymphadenectomy has no role.12 Intraoperative endoscopy is an additional consideration that may assist in the complete resection of the lesion, especially in cases where the tumor is small or difficult to identify laparoscopically. Risks of challenging resections due to suboptimal tumor location or patient factors such as body habitus or multiple comorbidities must be weighed with the benefits of obtaining definitive pathology, especially in an asymptomatic patient such as ours with a presumed benign lesion on biopsy. Conversations with the patient should explore these risks and benefits and possible misdiagnoses from imaging and biopsy to ensure shared decision-making.
Although uncommon, recurrence of the tumor is possible after resection, and we elected to follow up with a CT scan in one year. As this tumor type is exceedingly rare, there is no definitive recommendation for surveillance after resection. Most published case reports have similarly elected for repeat imaging one year after resection, and most report no recurrence at up to five years follow-up.3,6,13,14
Conclusion
Gastric schwannomas are a rare form of mesenchymal gastric tumor. Though the incidence is low, this tumor should be considered in the differential diagnosis when encountering patients with subepithelial, exophytic lesions of the stomach. Gastric schwannomas may be challenging to differentiate from GISTs based on imaging and clinical presentation, but clear histological and IHC markers can help identify this tumor. Gastric schwannomas typically stain positive for S-100, PCK-theta, and GFAP while staining negative for CD117 (c-KIT), DOG-1, and CD34. The diagnosis of a gastric schwannoma provides the patient with an excellent prognosis as these lesions are generally benign and do not invade lymphatics. Currently, the recommended treatment is complete surgical resection which is considered curative. As a result of this case, our institution has adjusted routine IHC staining of gastric tumors to include S-100, aiming to identify this pathology earlier and prevent delays to surgical resection.
Lessons Learned
Gastric schwannomas are an extremely rare type of GI mesenchymal tumor that should be considered in the differential diagnosis when encountering gastric masses. They often mimic the physical features of GIST but can be easily distinguished with S-100 immunohistochemical staining. It is crucial to correctly identify these lesions as they carry an excellent prognosis and surgical resection is generally curative.
Authors
Haase Ca,b; Khalafi Sa,b; Nguyen JAa,b; Arora KSc; Sleeman Da,b; Kutlu OCa,b
Author Affiliations
- DeWitt Daughtry Family Department of Surgery, Miller School of Medicine, University of Miami, Miami, FL 33136
- Department of Surgery, Jackson Memorial Hospital, Miami, FL 33136
- Department of Pathology and Laboratory Medicine, Miller School of Medicine, University of Miami, Miami, FL 33136
Corresponding Author
Shayan Khalafi, MD
Rosenstiel Medical Science Building
1600 NW 10th Avenue, Room 4022
Miami, FL 33136
Email: sxk1000@miami.edu
Meeting Presentation
American College of Surgeons South Florida Chapter, Fort Lauderdale, FL, 2020
Disclosure Statement
The authors have no conflicts of interest to disclose.
Funding/Support
The authors have no relevant financial relationships or in-kind support to disclose.
Received: August 31, 2020
Revision received: October 18, 2020
Accepted: November 1, 2020
References
- Bosman FT, Carneiro F, Hruban RH. et al eds. WHO Classification of Tumours of the Digestive System: Reflects the Views of a Working Group That Convened for an Editorial and Consensus Conference at the International Agency for Research on Cancer (IARC), Lyon, December 10-12, 2009 ; Third Volume of the 4th Edition of the WHO Series on Histological and Genetic Typing of Human Tumours. Lyon: IARC; 2010.
- Miettinen M, Lasota J. Gastrointestinal stromal tumors--definition, clinical, histological, immunohistochemical, and molecular genetic features and differential diagnosis. Virchows Arch. 2001;438(1):1-12. doi:10.1007/s004280000338
- Atmatzidis S, Chatzimavroudis G, Dragoumis D, Tsiaousis P, Patsas A, Atmatzidis K. Gastric schwannoma: a case report and literature review. Hippokratia. 2012;16(3):280-282.
- Kwon MS, Lee SS, Ahn GH. Schwannomas of the gastrointestinal tract: clinicopathological features of 12 cases including a case of esophageal tumor compared with those of gastrointestinal stromal tumors and leiomyomas of the gastrointestinal tract. Pathol Res Pract. 2002;198(9):605-613. doi:10.1078/0344-0338-00309
- Yoon W, Paulson K, Mazzara P, Nagori S, Barawi M, Berri R. Gastric schwannoma: a rare but important differential diagnosis of a gastric submucosal mass. Case Rep Surg. 2012;2012:280982. doi:10.1155/2012/280982
- Yoon HY, Kim CB, Lee YH, Kim HG. Gastric schwannoma. Yonsei Med J. 2008;49(6):1052-1054. doi:10.3349/ymj.2008.49.6.1052
- Takeda M, Amano Y, Machida T, Kato S, Naito Z, Kumita S. CT, MRI, and PET findings of gastric schwannoma. Jpn J Radiol. 2012;30(7):602-605. doi:10.1007/s11604-012-0093-4
- Drago J, Fuente I, Cavadas D, Beskow A, Wright F. Gastric Schwannoma. J Gastrointest Surg. 2019;23(2):381-383. doi:10.1007/s11605-018-3926-3
- Miettinen M, Sobin LH, Sarlomo-Rikala M. Immunohistochemical spectrum of GISTs at different sites and their differential diagnosis with a reference to CD117 (KIT). Mod Pathol. 2000;13(10):1134-1142. doi:10.1038/modpathol.3880210
- Miettinen M, Wang ZF, Lasota J. DOG1 antibody in the differential diagnosis of gastrointestinal stromal tumors: a study of 1840 cases. Am J Surg Pathol. 2009;33(9):1401-1408. doi:10.1097/PAS.0b013e3181a90e1a
- Fletcher CD, Berman JJ, Corless C, et al. Diagnosis of gastrointestinal stromal tumors: a consensus approach. Int J Surg Pathol. 2002;10(2):81-89. doi:10.1177/106689690201000201
- Shah AS, Rathi PM, Somani VS, Mulani AM. Gastric Schwannoma: A Benign Tumor Often Misdiagnosed as Gastrointestinal Stromal Tumor. Clin Pract. 2015;5(3):775. Published 2015 Oct 12. doi:10.4081/cp.2015.775
- Singh A, Mittal A, Garg B, Sood N. Schwannoma of the stomach: a case report. J Med Case Rep. 2016;10:4. Published 2016 Jan 15. doi:10.1186/s13256-015-0788-0
- Mekras A, Krenn V, Perrakis A, et al. Gastrointestinal schwannomas: a rare but important differential diagnosis of mesenchymal tumors of gastrointestinal tract. BMC Surg. 2018;18(1):47. Published 2018 Jul 25. doi:10.1186/s12893-018-0379-2